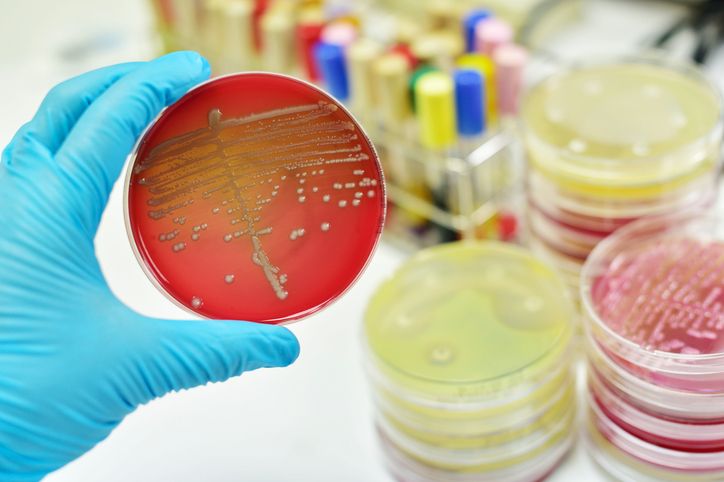
YENİ BİR ANTİBİYOTİK FAMİLYASI KEŞFEDİLDİ

-
BAŞBAKAN YILDIRIM:
EGE'DEKİ
GERGİNLİKTEN
RAHATSIZIZ -
DIŞİŞLERİ'NDEN KARDAK GERİLİMİNE
İLİŞKİN AÇIKLAMA -
TSK VE ÖSO
ARŞALİ KÖYÜNÜ
TERÖR ÖRGÜTÜ
PYD/PKK'DAN TEMİZLEDİ -
TSK: KUZEY IRAK'A HAVA HAREKATINDA
16 HEDEF İMHA EDİLDİ -
ABD'DEN SURİYE RAPORU
-
BÖRÜ'NÜN PÖH EKİBİ İLK KEZ KONUŞTU (BÖRÜ NE ZAMAN BAŞLIYOR?)
-
AK Parti-MHP ittifakında bugün liderlere sunum yapılacak
-
ABD, Rus yapımı bir tankı vurdu
-
Anayasa Mahkemesi'ne 173 bin bireysel başvuru
-
ABD Dışişleri Bakanı Tillerson'dan Afrin açıklaması
-
Macron'dan Suriye uyarısı: Vururuz!
-
"Rüşvet aldığına dair yeterli delil var"
-
Schulz görevinden istifa etti
-
Rusya'nın yeni nesil savaş makineleri
-
En pahalı şehirler belli oldu (Türkiye'den 3 kent var)
-
'Süper Bilgisayar'dan Bayern Münih-Beşiktaş maçı tahmini
-
"HAVUÇ'LU ÇEKİMLER BAŞLADI"(YAPIMCI DUYURDU)
-
VICTORIA'S SECRET MODELLERİ RIO'DA
-
SURVİVOR'DA ADA KONSEYİ ÖNCESİ İLK KAVGA
-
SILA'DAN "SEN DE BAŞINI ALIP GİTME" YORUMU
-
PODYUMDA GIGI VE BELLA HADID RÜZGARI
-
KAYBEDENLER KULÜBÜ'NDEN 14 ŞUBAT'A ÖZEL TANITIM
-
NUSRET'TEN DAVID BECKHAM'A ÖZEL SERVİS
-
ŞEHİR TİYATROLARI'NDA BU HAFTA 17 VAR
-
ZİRVE YİNE EL DEĞİŞTİRDİ (YABANCI DİZİLER)
-
KAYHAN, RECEP'İ GEÇEBİLDİ Mİ? (GİŞE RAKAMLARI)
-
ÇAĞLAR ÇORUMLU, 'YAŞAR USTA'YLA GÜLDÜRECEK
-
'BLUE MAN GPOUP' İSTANBUL SOKAKLARINDA
-
GRİPİN'Lİ SAHNE SÖZ'E DAMGA VURDU
-
'İÇİNDEN CAZ GEÇEN FİLMLER' BAŞLIYOR
-
ABDÜLHAMİD İLE İLGİLİ EN KAPSAMLI SERGİ
-
"DURU OLMADAN YAŞAYAMAM!"
-
GÖKHAN ÖZEN'İN YENİ DÖVMESİ
-
İSTANBUL İÇİN GERİ SAYIM (FESTİVAL DETAYLARI)
-
GODFATHER'DA NASIL GÖRÜNÜRDÜ?
-
GERÇEKLERLE YÜZLEŞME VAKTİ
KİM NEYİ ARIYOR?
-
- Türk vatandaşlarından vize istemeyen ülkeler (2018 güncel liste)
- Vatanım Sensin dizisi oyuncu kadrosu ve karakter analizleri (Vatanım Sensin'de kim, kimdir?)
- Uzaktan yüksek lisans eğitimi veren üniversiteler
- Haftalık burç yorumları (5-11 Şubat astroloji)
- Bitcoin nedir, nasıl alınır? Bitcoin madenciliği nasıl yapılır? (Bitcoin hakkında her şey)
- 'Yerli WhatsApp' PTT Messenger nedir? (PTT Messenger nasıl indirilir?)
- Diziler nerede çekildi?
- 2017'nin en iyi 10 filmi (IMDb verileri)
- 2018 ÖSYM sınav takvimi (YKS, KPSS, ALES, DGS, YDS ne zaman?)
- İstikamet 'Kızıl Elma' (Kızıl Elma ülküsü nedir?)
- KPSS 2018 sınav tarihi ne zaman?
- 2018'de kaç gün resmi tatil var?
- Üniversiteye girişte yeni sınav sistemi nasıl olacak? (Yükseköğretim Kurumları Sınavı - YKS nedir?)
- TEOG yerine ne geldi? (Madde madde liseye geçişte yeni sistem)
- Ufak Tefek Cinayetler dizisinin konusu ve oyuncu kadrosu
- Çukur dizisinin oyuncu kadrosu (Çukur konusu ve oyuncularının karakter analizleri)
- Söz dizisinde kim kimdir? (Oyuncu kadrosu,karakter analizi)
- Asgari Geçim İndirimi (AGİ) 2018'de ne kadar oldu? (AGİ hesaplama)